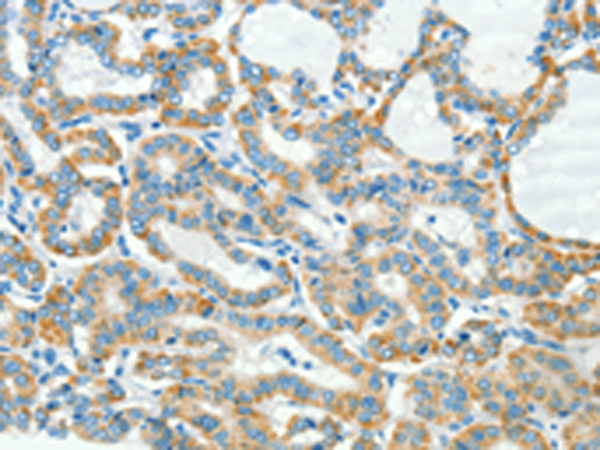

别名:S10; HSAS; MASA; MIC5; SPG1; CAML1; CD171; HSAS1; N-CAML1; NCAM-L1; N-CAM-L1应用:IHC
反应种属:Human, Mouse, Rat
规格:50μl/100μl
| Description |
|---|
| The protein encoded by this gene is an axonal glycoprotein belonging to the immunoglobulin supergene family. The ectodomain, consisting of several immunoglobulin-like domains and fibronectin-like repeats (type III), is linked via a single transmembrane sequence to a conserved cytoplasmic domain. This cell adhesion molecule plays an important role in nervous system development, including neuronal migration and differentiation. Mutations in the gene cause X-linked neurological syndromes known as CRASH (corpus callosum hypoplasia, retardation, aphasia, spastic paraplegia and hydrocephalus). Alternative splicing of this gene results in multiple transcript variants, some of which include an alternate exon that is considered to be specific to neurons. |
| Specification | |
|---|---|
| Aliases | S10; HSAS; MASA; MIC5; SPG1; CAML1; CD171; HSAS1; N-CAML1; NCAM-L1; N-CAM-L1 |
| Swissprot | P32004 |
| Host/Isotype | Rabbit IgG |
| Storage | Store at 4°C short term. Aliquot and store at -20°C long term. Avoid freeze/thaw cycles. |
| Species Reactivity | Human, Mouse, Rat |
| Immunogen | Synthetic peptide of human L1CAM |
| Formulation | pH7.4 PBS, 0.05% NaN3, 40% Glycerol |
| Application | |
|---|---|
| IHC | 1/25-1/100 |
| ELISA | 1/2000-1/5000 |
![]() |
The image is immunohistochemistry of paraffin-embedded Human liver cancer tissue using P11549(L1CAM Antibody) at dilution 1/40. (Original magnification: ×200) |
![]() |
The image is immunohistochemistry of paraffin-embedded Human thyroid cancer tissue using P11549(L1CAM Antibody) at dilution 1/40. (Original magnification: ×200) |
本公司的所有产品仅用于科学研究或者工业应用等非医疗目的,不可用于人类或动物的临床诊断或治疗,非药用,非食用。
暂无评论
本公司的所有产品仅用于科学研究或者工业应用等非医疗目的,不可用于人类或动物的临床诊断或治疗,非药用,非食用。
中文

发表回复